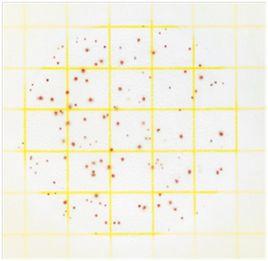
菌落總數測試片

定義
食品檢樣經過處理,在一定條件下(如培養基、培養溫度和培養時間等)培養後,所得每g(ml)檢樣中形成的微生物菌落總數。它套用於所有的食品,主要用於評估大多數食品的總的細菌含量水平。
背景
測試片檢測方法有操作簡單,檢測周期短等優點,它一旦投入使用,將大大縮短檢測周期,簡化實驗操作並取得較大的經濟收益,目前已被國內很多食品工廠所認可並使用。位列美國前100強的80多家食品廠,都在使用3M Petrifilm™測試片來進行微生物的檢測。
測試片介紹
原理
Petrifilm™測試片是美國3M公司發明的一種進行菌落計數的乾膜,採用可再生的水合物材質,由上下兩層薄膜組成。上層聚丙烯薄膜含有粘合劑、指示劑及冷水可溶性凝膠;下層聚乙烯薄膜含有細菌生長所需的營養瓊脂培養基。細菌在測試片上生長時,細胞代謝產物與上層的指示劑TTC發生氧化還原反應,將指示劑還原成紅色非溶解性產物三苯甲臢,從而使細菌著色。故測試片上紅色菌落判斷為菌落總數。具體方法詳見行業標準SN/T 1897-2007食品中菌落總數的測定Petrifilm™測試片法。
適用範圍
具體的適用範圍如圖所示:
適用範圍使用方法
菌落總數測試片的使用方法如圖:
步驟1
步驟2
步驟3
步驟4存放
測試片的存放:測試片建議在冷藏條件下存放(2~8℃),開封后的測試片應使用透明膠帶密封后,常溫、避光、乾燥保存。並在1個月內使用完。